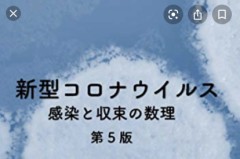
短冊に書きたい

- 名前
- みい(..)
- 性別
- ♀
- 年齢
- 54歳
- 住所
- 海外
- 自己紹介
- カラダの関係は求めていません。 会話を好みます。(特に 同性は嬉しいです) 最近まで...
JavaScriptを有効にすると、デジカフェをより快適にご利用できます。
ブラウザの設定でJavaScriptを有効にしてからご利用ください。
短冊に書きたい
2020年07月07日 12:50
なんか 裏っぽい話題では ないので、そのままに答えましょう。
コロナ収束。 終息 とまでは言いませんが(出来たらして欲しいけど)
もうね、都内に始まり 近所でさえスーパーでさえ 散歩でさえ家族の心配を背に受けながら 出掛けるメンタルなくて 篭りがち。
だからなのか 最近なんとなく気分的にスッキリしないで、ダンナの在宅とか 主探しの頓挫とか いろいろ言い訳してたけど…
気が付きました!トキメキが足りない んだと。
以前はこんな外出控えなんてない時は ふらーっと買い物に行った先での携帯屋さん、ディーラーさん、販売員さん、リアル友 に至るまで いい感じかも(≧∀≦) って人と お喋りしに ふらふら出掛けていたんですよ笑。でもこのコロちゃん騒動以来、ゲーム友にも会えず… バトルはリモート操作が出来るようになって支障はないんですが、「人」に会えない。
かまってちゃん的にツラい 泣
昨日はスーパーで見かけたゲーム友さん(男性)に こちらから声かけ 笑。久しぶりに会えたからか 嬉しくて気付いたんです。そっかトキめいてない んだと。
ってことで すっごい勇気を出して メールしてみたけど… その気はない、ってこと?
変態オバさんですものね…。ぐすん、寂しいわん 泣
ボチボチ逝きます
追伸
(ウトウトしながら 描いてました。いま気がついた。ボチボチ逝きます って何?! 自分にツッコミ笑。描き直そうか迷ったケド面白いからこのままにしまーす)pm 2:00なう

このウラログへのコメント
コメントを書く